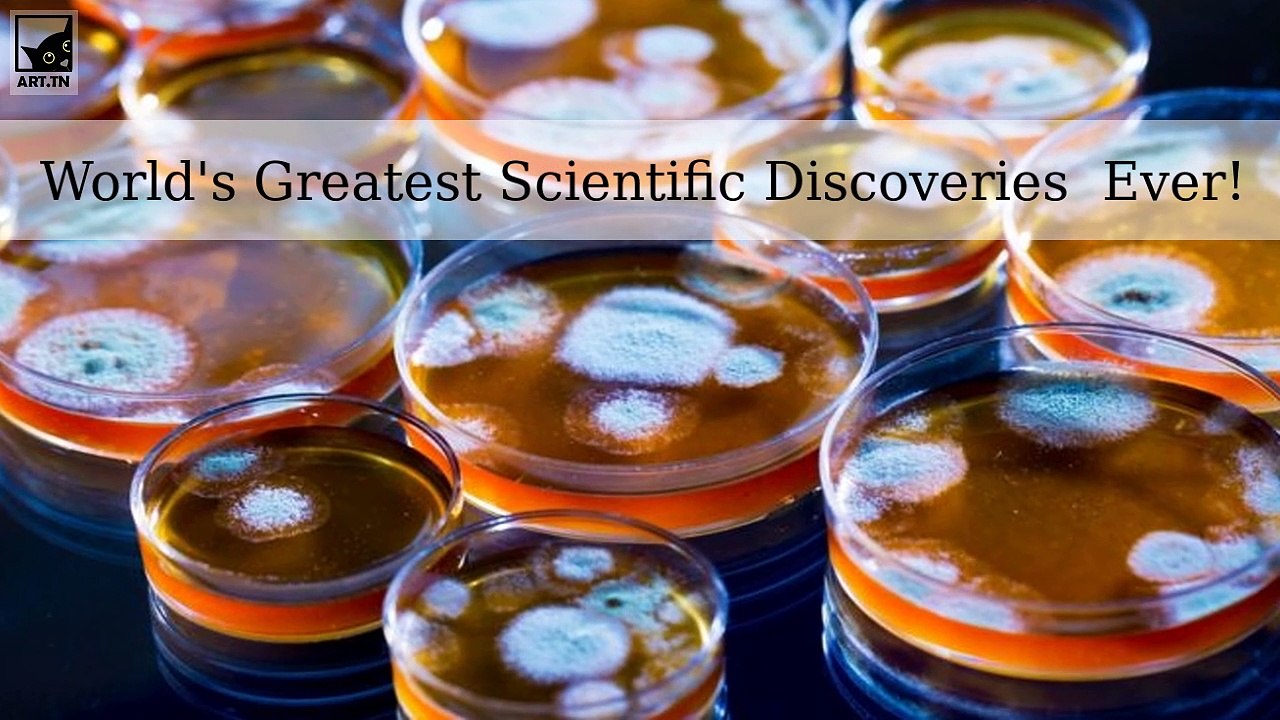
World's Greatest Scientific Discoveries And Inventions Ever!

Search Results for "Computing discoveries"
Find videos related to your search query. Browse through our collection of videos matching "Computing discoveries". Search across titles, descriptions, tags, and channels to discover the content you're looking for.
Search Results for "Computing discoveries"
50 results found

14:46
what is cloud computing | cloud computing explained | cloud computing in bangla | amader canvas
Amader Canvas
29.9K views

6:24
Cloud Computing In 6 Minutes | What Is Cloud Computing? | Cloud Computing Explained | Simplilearn
Simplilearn
2.9M views

0:46
Astonishing Discoveries Inside the Voynich Manuscript
TechandTrek
457 views

1:04
The First Discoveries In Human History By Muslim Scientists#shorts #shortsfeed #viral #education
MRSNS25
1.2K views

13:19
Top 15 New Discoveries MADE By AI
AI Uncovered
236.2K views

1:03
Greatest Discoveries In The World #shorts #aihistory
AI HISTORY
4.9M views

6:20
Kid Genius Brielle Shares Her Scientific Discoveries
TheEllenShow
23.2M views

0:32
The Arabic Influence on the Stars Unveiling Ancient Discoveries
Room of Wisdom
3.8K views

0:22
"5 Groundbreaking Discoveries That Changed Mathematics Forever!" #greatestdiscovery #mathematics
HistoricalFlair
170 views

22:53
25 Biggest Discoveries in Space Exploration
List 25
24.6K views

43:08
Hidden Secret of the Ancient Discoveries and Science │ History Documentary │
Diedra Gamez
11 views

0:21
The Man Who Knew Too Much Alan Turing and the Invention of the Computer Great Discoveries Pdf
judefrancisco
5 views

12:17
10 Incredible Recent Discoveries | Amazing discovery |
Sab Kuch Online
8 views

7:29
Latest Science Discoveries|Exploratory Research|Amazing Science Facts|Undiscovered Truth Study Motivation|Discover Treasure| Interesting Science Facts| Discovery Video| Discover The World
levelup4u
1 views

2:01
Forbidden Archeology: The Discoveries They Don't Want You to Know About
Secrets of the World
5 views

0:36
Breaking News: New Discoveries in Alan Turing's Legacy!
Turing Tales
440 views

20:25
Elon Musk Details DOGE’s Most Shocking Discoveries — and Why AI Is Key to Solving the Debt Crisis
JRE Clips
451.4K views

4:09
The Story of Math: How Ancient Discoveries Shaped Modern Mathematics
Math Deciphered
25.6K views

0:18
Intriguing Discoveries with AI in Manuscript Analysis 🤖
Oddities uncovered
14 views

2:31
Answer in the Desert: 5 Most Incredible Discoveries of the Week
News_Now
8 views

1:56:30
Scientific Discoveries So Insane, They Sound Like Pure Fantasy
Bright Side
6.3K views
3:54
World's Greatest Scientific Discoveries And Inventions Ever!
Curious Cat
2 views

15:07
5 New Scientific Discoveries in 2024
Today Science
187 views

43:08
Ancient Discoveries: Secret Science Of The Occult (documentary)
elbellavistas
73 views

0:39
Full version 100 Greatest Science Discoveries of All Time Review
rohacagofo
3 views

12:51
Top 10 Unexplained Discoveries That Could Change the World Forever
WatchMojo
19 views

1:19:35
To Reach the Nearest Stars Space Documentary, Latest Space Discoveries
Aliens At Work
89 views

8:18
10 AMAZING Archaeological Discoveries
jasonelizabeth8279
36 views

20:49
Top 20 Most Controversial Discoveries In History
WatchMojo.com
154.6K views

49:05
The Out of Bounds Discoveries Iceberg Explained
sourcebrew
558.5K views

3:02:17
Unusual Discoveries Wrapped in the Unexplained
Bright Side
1.4K views

30:27
20 Most Amazing Discoveries From World War II
Incredible Stories
1.2M views

3:00:49
Unexplained Mysteries and Discoveries From Ancient History to Current Time
Bright Side
2.1K views

11:39
Top 10 Unexplained Archaeological Discoveries
WatchMojo
2.8K views

10:56
Top 10 Scariest Archaeological Discoveries Ever
WatchMojo
1.6K views

37:01
Top 30 Greatest Archaeological Discoveries Ever
WatchMojo
4.1K views

16:00
Shocking New Discoveries in the PHILIPPINES Scared Scientists Worldwide
HiddenMysteries
204 views

3:03:31
Discoveries So Unusual You’d Think Were Made Up
Bright Side
427 views

33:28
The Map of Quantum Computing - Quantum Computing Explained
Domain of Science
2.2M views

0:45
What Is Quantum Computing #quantum #quantumcomputing #youtubeshorts #computing
Teq nest
115 views

0:57
Quantum Computing vs. Classical Computing – What’s the Future?
Bharath The Seeker
59 views

0:20
Do You Prefer Math or Computing? #coding #olevel #secondary #computing #olevelexam
Academy of Computing: Master Python
478 views

0:47
Should Students Take Computing as an O-level Subject? #olevel #secondary #computing
Academy of Computing: Master Python
534 views

0:26
Which Secondary Schools Offer Computing? #secondary #olevel #computing #sg #shorts
Academy of Computing: Master Python
88 views

0:47
Colossus and the development of electronic computing #computing #colossus #cryptography #ww2
The Centre for Computing History
1.1K views

0:10
How is O-Level Computing Tested? #secondary #computing #olevel #coding #python
Academy of Computing: Master Python
90 views

6:24
Cloud Computing Online Training | India | Cloud Computing Videos | Ecorptrainings
Ecorptrainings
45 views
![[CS] - Cloud Computing What is Cloud Computing](/image/s2.dmcdn.net/v/9UxjC1clU7uFPqPRu/xx720.pagespeed.ic.-vajmNbkVr.jpg)
4:42
[CS] - Cloud Computing What is Cloud Computing
Jerri Houck
2 views

4:42
Cloud Computing: What is Cloud Computing?
Zackary Wallen
7 views

18:00
Social Computing: Introduction to Social Computing
Melthypnotic
3 views